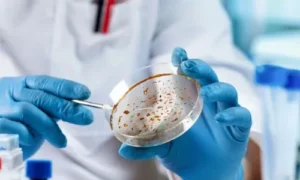
Prevention and Control of Microbial Diseases

Microorganisms are microscopic living organisms that are not visible to the naked eye. They can only be viewed using a microscope. Despite their diminutive size, they have a significant impact on our lives, ranging from aiding digestion to triggering fatal infections. Microorganisms can be found in many environments, including the air, water, soil, and even our own bodies.
Also See: Harmful Microorganisms Explained
What are microorganisms?

Microorganisms, often known as microbes, are living organisms that are too small to view without a microscope. They can be single-celled (as bacteria) or multicelled (like some fungi). These organisms can be found in a variety of environments, including hot springs, glaciers, oceans, and even inside living humans.
Types of Microorganisms

1. Bacteria
- Bacteria are single-celled organisms.
- They come in different shapes — round (coccus), rod (bacillus), and spiral (spirillum).
- Useful bacteria help in making curd, cheese, and medicines.
- Harmful bacteria cause diseases like typhoid, tuberculosis, and cholera.
2. Fungi
- Fungi can be unicellular (like yeast) or multicellular (like mould and mushrooms).
- Useful fungi help in making bread (yeast fermentation) and antibiotics (penicillin).
- Harmful fungi spoil food and cause infections like ringworm.
3. Protozoa
- Protozoa are animal-like microorganisms.
- They usually live in water.
- Examples: Amoeba, Paramecium.
- Some protozoa cause diseases like malaria and dysentery.
4. Algae
- Algae are plant-like microorganisms that contain chlorophyll.
- They make their own food through photosynthesis.
- Examples: Chlamydomonas, Spirogyra.
- Some algae are used in food and cosmetics.
5. Viruses
- Viruses are the smallest of all microorganisms.
- They can reproduce only inside the living cells of other organisms.
- Examples: Influenza virus, HIV, Coronavirus.
- They cause diseases in humans, animals, and plants.
Beneficial Uses of Microorganisms

1. In the Food Industry
- Bacteria like Lactobacillus convert milk into curd.
- Yeast helps in baking bread and cakes by producing carbon dioxide.
2. In Medicine
- Antibiotics like penicillin are made from fungi.
- Vaccines are developed using weakened or dead microorganisms to prevent diseases.
3. In Agriculture
- Some bacteria fix nitrogen in the soil, making it fertile.
- Example: Rhizobium found in the roots of leguminous plants.
4. In Cleaning the Environment
- Microorganisms decompose dead plants and animals into simpler substances.
- This process recycles nutrients back into the soil.
Harmful Effects of Microorganisms
- Cause diseases in humans (e.g., cholera, malaria, influenza)
- Spoil food, making it unsafe to eat
- Cause plant diseases that reduce crop yield
Prevention and Control of Microbial Diseases
1. Maintain personal hygiene
2. Eat well-cooked and covered food
3. Wash hands regularly
4. Get vaccinated on time
5. Keep the surroundings clean to avoid the breeding of mosquitoes and flies
Conclusion
Microorganisms are both allies and enemies. They assist us in producing food, medication, and keeping our environment clean, but some also cause diseases. Understanding microbes allows us to use them appropriately and protect ourselves from their negative consequences.




